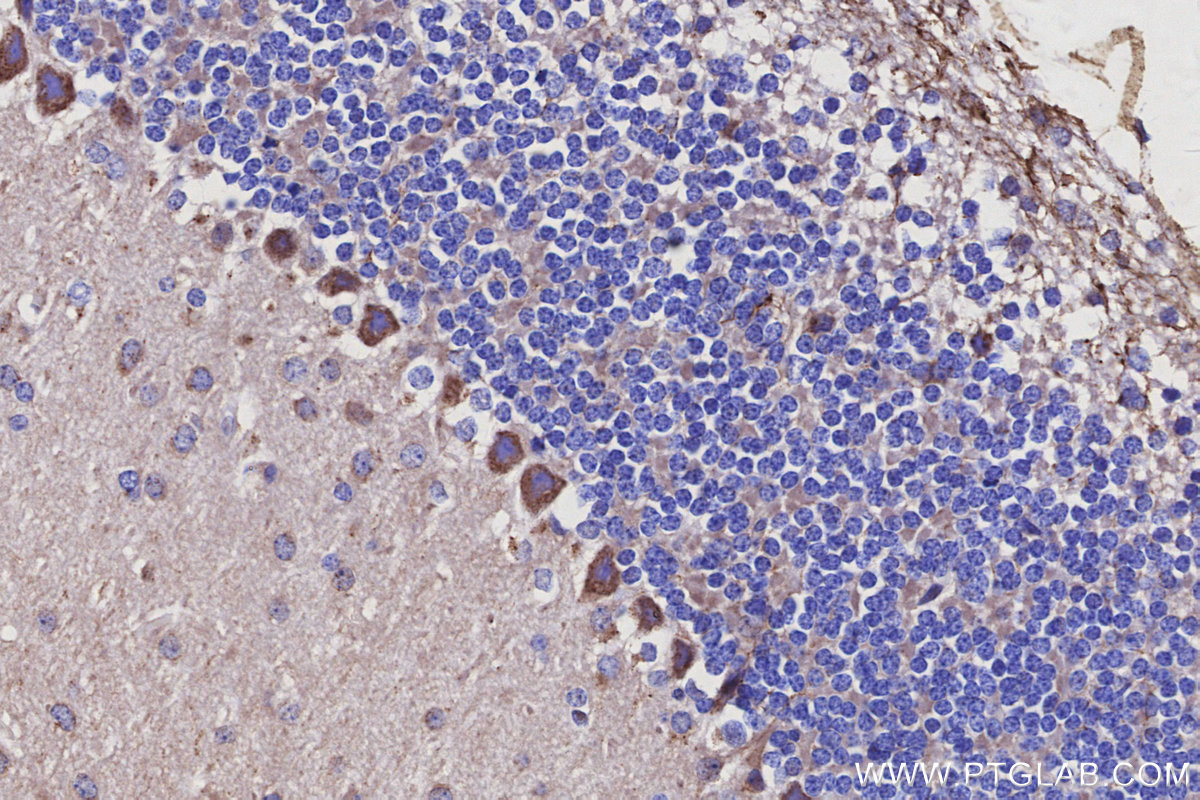
Immunohistochemical analysis of paraffin-embedded mouse cerebellum tissue slide using KHC3115 (LRRC1 IHC Kit). Immunohistochemical analysis of paraffin-embedded mouse cerebellum tissue slide using KHC3115 (LRRC1 IHC Kit).

IHCeasy® LRRC1 Ready-To-Use IHC Kit
LRRC1 Ready-to-use reagent kit for IHC.
Reactivity
Human, Mouse
Sample Type
FFPE tissue
Cat no : KHC3115
Synonyms
LANO, LANO adapter protein, LAP and no PDZ protein, Leucine-rich repeat-containing protein 1
Validation Data Gallery
Product Information
KHC3115 is a ready-to-use IHC kit for staining of LRRC1. The kit provides all reagents, from antigen retrieval to cover slip mounting, that require little to no diluting or handling prior to use. Simply apply the reagents to your sample slide according to the protocol and you're steps away from obtaining high-quality IHC data.
| Product name | IHCeasy® LRRC1 Ready-To-Use IHC Kit |
| Sample type | FFPE tissue |
| Assay type | Immunohistochemistry |
| Primary antibody type | Rabbit Polyclonal |
| Secondary antibody type | Polymer-HRP-Goat anti-Rabbit |
| Reactivity | Human, Mouse |
Kit components
| Component | Size | Concentration |
|---|---|---|
| Antigen Retrieval Buffer | 100 mL | 50× |
| Washing Buffer | 100 mL ×2 | 20× |
| Blocking Buffer | 5 mL | RTU |
| Primary Antibody | 5 mL | RTU |
| Secondary Antibody | 5 mL | RTU |
| Chromogen Component A | 0.2 mL | RTU |
| Chromogen Component B | 4 mL | RTU |
| Signal Enhancer | 5 mL | RTU |
| Counter Staining Reagent | 5 mL | RTU |
| Mounting Media | 5 mL | RTU |
| Datasheet | 1 Copy | |
| Manual | 1 Copy |
Background Information
LRRC1 consists of 524 amino acids including 16 leucine-rich repeats and a LAP-specific domain. It has been shown to be highly expressed in several human cancers and can participate in the malignant process of cancer cells, such as hepatocellular carcinoma, breast cancer and non-small cell lung cancer.
Properties
| Storage Instructions | All the reagents are stored at 2-8°C. The kit is stable for 6 months from the date of receipt. |
| Synonyms | LANO, LANO adapter protein, LAP and no PDZ protein, Leucine-rich repeat-containing protein 1 |